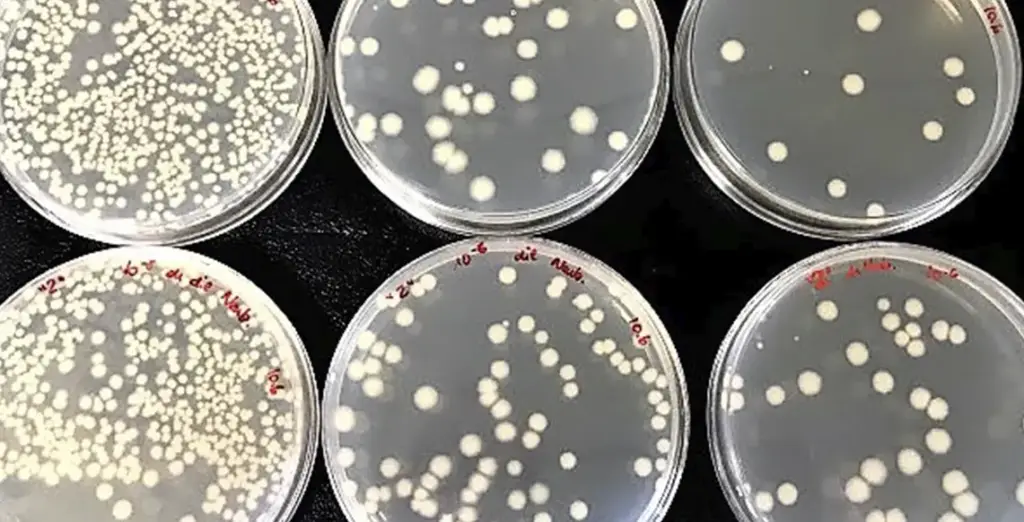

Bioinsecticidal proteins from Bacillus thuringiensis
Our research integrates mechanistic studies of Bacillus thuringiensis toxins and their interactions with insect targets with the discovery and development of novel biological control agents. This combined basic and applied approach aims to support the design of more effective and durable strategies for insect resistance management within Integrated Pest Management programs.

Subtopics:
1 Basis of resistance to insecticidal proteins
Understanding of the mechanisms by which B. thuringiensis toxins work
and how insects can develop resistance to them.
Athe active form of the protein, the characterisation of the membrane receptors, determining whether two or more toxins bind to the same binding sites, determining whether midgut cells react against the damaged infringed by the Bt toxins, etc. We are particularly interested in contributing to the detailed understanding of the mode of action of the Vip3 proteins, for which much less information is available compared with some of the best studied Cry proteins. Developing “binding sites models” is a very useful tool to determine which combinations of Bt proteins would not be advisable from the resistance management standpoint. The understanding of how two toxins interact in a particular pest allows us to make predictions on the possible appearance of cross-resistance to other Bt toxins. Two toxins that share the binding site in a membrane receptor can become simultaneously useless if the binding site changes by mutation. In that case both toxins, though different, would share a critical step in the mode of action and therefore its combination in the same Bt crop would be advised against. It is important to note that for this objective we do not require to work with resistant insects. We perform in vivo competition experiements (feeding larvae with one toxin at increasing concentratios of a second inactivated toxin) to validate generated binding site models. To validate that a putative receptor is a functional receptor of Bt toxins we are using insect cultured cells as a model system. If a type of cells is not susceptible to a given Bt toxin, the transformation with the gene for a putative membrane receptor protein serves as a way to test its functionality. We have studied the mode of action of Bt toxins in many insect pests, all of them belonging to the Lepidoptera order.

Discovery, engineering and development of novel bacterial and viral agents
to be used as bioinsecticides for the control insect pests.
The development of effective biological control agents against pests can significantly reduce or eliminate the need for chemical pesticides and contributes greatly to the implementation of programs of Integrated Pest Management (IPM). Bio-insecticides based on Bacillus thuringiensis (Bt) are a safe and effective method for the control of many agricultural and forest pests and represent 95% of bio-insecticides marketed worldwide. Moreover, Bt genes which codified pesticidal proteins have been implented in transgenic crops for pest autoprotection.
Some advantages of using Bt and its insecticidal proteins in the fight against insects are, on the one hand, their specificity, since one can target the insect pest without affecting the populations of beneficial insects and, on the other hand, they are innocuous to organisms other than insects, including humans. These characteristics make Bt a resource very appreciated from the standpoint of the organic farming. Actually, they are of the very few insecticides allowed in this type of agriculture.
New pesticide formulations are required to broaden the current protection spectrum and also to combat the ever arising problem of insecticide resistance. The continuous use of pesticides eventually select for resistance genes in the treated populations. In fact, as with chemical insecticides, resistance to Bt has also evolved in insect populations heavily treated with this type of microbial insecticide.
This aspect of our research is the one with the highest application to the industrial sector. We have collaborative projects with the most relevant laboratories and companies in the field, both within and outside Spain. Our research is focused to control the most damaging lepidopteran pests in greenhouse and the open field, such as Spodoptera exigua, Helicoverpa armigera, Ostrinia nubilalis and Plutella xylostella. Our University provides us with the facilities that allow us to work in this field of research and our laboratory has become a reference laboratory in this topic.
2.1 Discovery of novel B. thuringiensis strains with upgraded properties
The development of new bioinsecticides with high activity against a group of insect pests is a primary target to improve the economic level of use. However, other aspects such as broad insecticidal spectrum and an alternative to the current ones to which insects have evolved resistance is also an important issue. For this reason, we include in our objectives the discovery of strains with a activity to pest species from different clades (i.e,. hemiptera, nematoda,…) and with activity against pest species with either none or just few toxic strains reported to date.
We currently hold several collections of Bt isolates (making a total of around 1000 isolates) and we keep increasing their number with samples from different parts of the world. The characterization of the microbiological and the insecticidal activity of the strains is a goal to provide novel material for new formulations. In addition, new properties of the strains of interest for the industry, such as the set of genes they contain, levels of insecticidal protein expression, lack of non-specific toxic agents, and the ease of growth in cheap culture media, are also key aspects for their transfer to the industry. We hold two patents on two of the most toxic isolates against lepidopterans.
The main distinctive insecticidal properties of B. thuringiensis lays on the production of specific proteins. The best known ones are accumulated during the sporulation phase in a compact aggregate in the parasporal body called “crystal”. Then, proteins present are called crystal proteins (or Cry proteins). In addition, other proteins are released in the vegetative phase (vegetative insecticidal proteins, or Vip) and they are not structurally related to the previous ones.
Cry or Vip proteins are not homogeneous groups and they are classified in more than 70 Cry types and 4 Vip types at the present moment. New NGS technologies are providing an increasing number of genes for which no studies on their expression or pesticidal characterization has been carried out. It has been reported some association about the type of gene and the toxicity to a group of insects (i.e., proteins of the Cry1A group are toxic to Lepidoptera), so it is possible to look for a gene toxic for a target in a group of genes with no known member toxic for such species.
The finding of novel genes that codify for novel insecticidal proteins will allow improving both Bt-based insecticides and Bt-crops (crops protected from insect attack by expressing a gene from Bt). Different screening programs based on protein gene detection and protein expression are being carried out resulting in the discovery of several novel genes, which are being cloned, sequenced and expressed to determine their insecticidal potential. We have an especial interest on new types of proteins from poorly characterized families.
2.3 Study of improving products formulation
Biopesticide formulated products contain the active material and other components, which are involved in the final performance of the product. The study of the interactions among the different components in the final product can provide us with clues about which elements interact with in an additive, synergistic or antagonistic way. The commercial products based on B. thuringiensis as the active ingredient contain a mixture of crystals and spores obtained as an end product of the fermentation process. However, it is worth to note that Bt, when it infects the larva, can produce other insecticidal compounds during the vegetative phase of growth. We are also studying the way to incorporate these compounds into the final product.
Other components of the formulation can potentiate the toxicity, i.e. the spore. We are particularly interested in the BtBs proteins (from insects) that have been described to synergize Cry proteins and from which a product has already been registered in the USA. These kind of proteins can be added to Bt formulations or expressed in transgenic crops along with cry genes.

Principal Investigators
Research projects
Selected publications
Shared midgut binding sites for Cry1A.105, Cry1Aa, Cry1Ab, Cry1Ac and Cry1Fa proteins from Bacillus thuringiensis in two important corn pests, Ostrinia nubilalis and Spodoptera frugiperda.
Hernández-Rodríguez, C.S.; Hernández-Martínez, P.; Van Rie, J.; Escriche, B.; Ferré, J. (2013). PLoS ONE 8: e68164 doi:
Characterization of the resistance to Vip3Aa in Helicoverpa armigera from Australia and the role of midgut processing and receptor binding
Chakroun, M.; Banyuls, N.; Walsh, T.; Downes, S.; James, B.; Ferré, J. (2016). Scientific Reports 6: 24311 doi:
The independent biological activity of Bacillus thuringiensis Cry23Aa protein against Cylas puncticollis
Hernández-Martínez, P., Khorramnejad, A., Prentice, K., Andrés-Garrido, A., Vera-Velasco, N. M., Smagghe, G., & Escriche, B. (2020). Frontiers in Microbiology, 11, 1734.
Molecular architecture and activation of the insecticidal protein Vip3Aa from Bacillus thuringiensis
Núñez-Ramírez, R, Huesa, J, Bel, Y, Ferré, J, Casino, P, Arias-Palomo, E (2020). Nature Communications 11: 3974 doi: 10.1038/s41467-020-17758-5.
Hetero-oligomerization of Bacillus thuringiensis Cry1A proteins enhance binding to the ABCC2 transporter of Spodoptera exigua
Pinos, D., Joya, N., Herrero, S., Ferré, J., & Hernández-Martínez, P. (2021). Biochemical Journal, 478(13), 2589-2600.
Mechanisms of resistance to insecticidal proteins from Bacillus thuringiensis
Jurat-Fuentes, J.L., D.G. Heckel and J. Ferré (2021). Annual Review of Entomology 66: 121-140 doi:
https://www.annualreviews.org/doi/abs/10.1146/annurev-ento-052620-073348
Response mechanisms of invertebrates to Bacillus thuringiensis and its pesticidal proteins
Pinos, D., A. Andrés-Garrido, J. Ferré and P. Hernández-Martínez (2021).Microbiology and Molecular Biology Reviews 85 doi: 10.1128/MMBR.00007-20
Vip3 insecticidal proteins: Structure and mode of action
Ferré, J; Bel, Y; Lázaro-Berenguer, M; Hernández-Martínez, P (2023). Advances in Insect Physiology 65: 93-122 doi: 10.1016/bs.aiip.2023.09.006
Bacillus thuringiensis Cry5, Cry21, App6 and Xpp55 proteins to control Meloidogyne javanica and M. incognita
Bel, Y., Galeano, M., Baños-Salmeron, M., Andrés-Anton, A. y Escriche, B. (2024). Applied Microbiology and Biotechnology, 108: 525. doi: 10.1007/s00253-024-13365-2.
Enhancing insecticidal efficacy of Bacillus thuringiensis Cry1Ab through pH-sensitive encapsulation
Jalali, E., Bel, Y., Maghsoudi, S., Noroozian, E., Escriche, B (2023). Applied Microbiology and Biotechnology 107: 6407-6419. doi: 10.1007/s00253-023-12723-w

